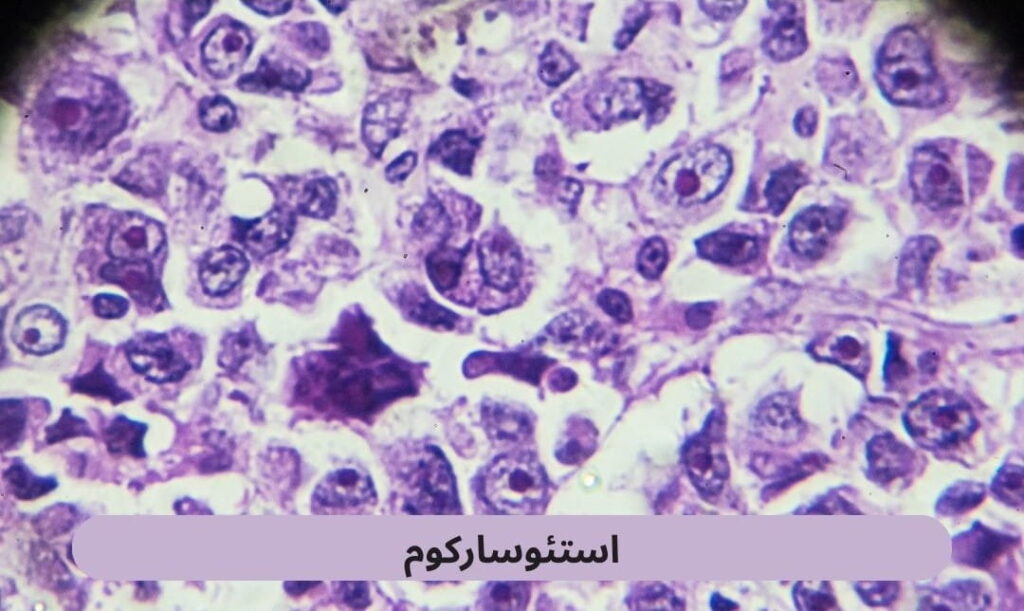
استئوسارکوم یا سارکوم استئوپلاستیک شایعترین نوع سرطان استخوان اولیه است که حدود ۲۰ درصد از کل تومورهای بدخیم استخوانی را شامل میشود.

پزشکی لند بانک اطلاعات پزشکی
تعداد وسیعی از مراکز پزشکی، درمانی، بیمارستان و کلینیکهای درمانی و زیبایی را مشاهده کنید، مقایسه کنید و با اطمینان بیشتر انتخاب کنید. آخرین و بروزترین مقالههای پزشکی و سلامت و زیبایی را بخوانید و آگاهانهتر از سلامتی و زیبایی خودتان مراقبت کنید.
خدمات پزشکی

مراکز دامپزشکی
مراکز دندانپزشکی
کلینیکهای زیبایی
مراکز تصویربرداری

کاشت مو و ابرو

مراکز قلب و عروق

کلینیکهای لاغری

کلینیکهای درد
پلتفرم نوبت دهی آنلاین پزشکی لند
پزشکی لند به عنوان یک پلتفرم منحصربهفرد نوبت دهی اینترنتی و سیستم مدیریت جامع آنلاین مراکز پزشکی و پزشکان عمل میکند. دید کلی ما دسترسی آسان کاربران به مجموعه کاملی از مراکز پزشکی و زیبایی است تا بتوانند خارج از مشکلات احتمالی به نیازهای پزشکی خود در سریع ترین زمان و با بالاترین دقت و اطمینان دست پیدا کنند.